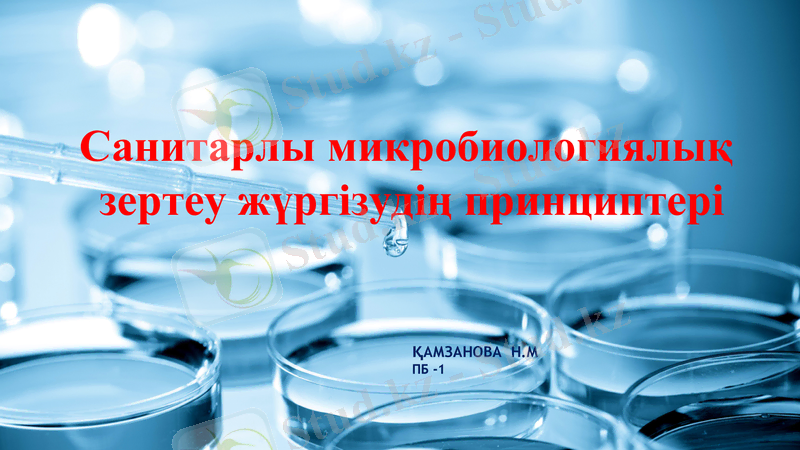
Slide 1

Санитарлы-микробиологиялық зерттеулер: принциптері, тікелей және жанама әдістері, көрсеткіштері мен сүттің микробиологиялық ластануы

Санитарлы микробиологиялық
зертеу жүргізудің принциптері
ҚАМЗАНОВА Н. М
ПБ -1

Жоспары
1. Санитарлық микробиология
2. Микробиологияда зерт. обьектілерді
санитарлы-эпидемиологиялық бағалаудың 2 əдісі қолданылады
3. Патогенді микроорганизмдерді тікелей анықтау əдісі.
4. Патогенді микроорганизмдерді жанама анықтау əдісі.
5. Санитарлы-микробиологиялық зерттеулердің принциптері.

Санитарлық микробиология - қоршаған орта объектілерінің (су, ауа, топырақ, сонымен қатар тағамдық өнімдер) микрофлорасын жəне оның адам денсаулығына əсерін зерттейді. Бұл ғылым медициналық микробиологияның эпидемиология мен гигиена салаларының аралас шектерін қамтитын саласы. Санитарлы - микробиологияның негізгі əдістеріне оригинальді осы саланың əдістері мен қатар жалпы жəне медициналық микробиологияның əдістері жатады. Бұл əдістер зерттелетін объектілерде жалпы микробтық санды(ЖМС), санитарлы - көрсеткіш микроорганизмдерді (СКМ) анықтауға, патогенді микроорганиздерді анықтау жəне олардың метоболиттерін табуға жəне сапасыздығын (зер. обектілеріндің микроорганизмдермен көп мөлшерде ластануы - сапасыздық деп алынды) анықтауға бағытталады.

Микробиологияда зерт. обьектілерді санитарлы-эпидемиологиялық бағалаудың 2 əдісі қолданылады:
Патогенді микроорганизмдерді тікелей анықтау əдісі
Патогенді микроорганизмдерді жанама анықтау əдісі

Патогенді микроорганизмдерді тікелей анықтау əдіс - салыстырмалы дəл, сенімді көп еңбекті талап етеді. Тікелей əдіс зерттелетін материалды қоректік ортаға егу арқылы бактериологиялық зерттеу, нуклеин қышқылдарының гибридизациясы, полимеразалық тізбекті реакция, серологоиялық, биологиялық т. б. əдістер. Дегенмен, тікелей анықтау əдісі нəтижесіне келесі факторлар əсер етеді:
1. Қоршаған ортада патогенді микроорганизмдердің қоршаған орта микрофлорасының 1/30 000 ғана құрайды. Сонымен патогенді микрофлора қоршаған ортада біркелкі таралмаған, сондықтан белгілі бір периодтық динамикада қажетті сериялық зерттеу жүргізіп отырады.
2. Бір қоздырғышты бөліп алу, басқа патогенді түрдің болуына кепілдік бола алмайды. Бұл жағдайда эпидемиялық ошақтарды тудыруға қабілетті шартты-патогенді микроорганизмдердің рөлі жоғарылайды.

Патогенді микроорганизмдерді жанама анықтау əдіс (жалпы микробтық сан, санитарлы көрсеткіш микроорганизмдер саны) - бұл қоршаған ортада қоздырғыштың болу мүмкіндігін жанама түрде анықтау. Жанама анықтау əдісінде 2 көрсеткіш қолданылады:
1. Жалпы микробтық сан - ЖМС -
2. Санитарлы - көрсеткіш микроорганизмдер саны - СКМ
1. Жалпы микробтық сан - 1 г. немесе 1 мл. субстраттағы микробтардың жалпы саны. Петри табақшадағы қатты қоректі орталарда өсіп шыққан колония түзі бірліктердің жалпы саны. Зерттелетін объектідегі мезофильді аэробты факультативті анаэробты микроорганиздердің саны (МАФАнМ) анықталады. Органикалық заттармен ластанған орталарда ЖМС жоғары болады немесе ЖМС - ның жоғары мəні ортаның органикалық ластанғандығын көрсетеді яғни мұндай орталарда патогенді микроорганизмдердің болу ықтималдығы жоғарылайды. ЖМС жылдам анықта үшін микроскоп арқылы немесе арнайы электорндық есептегіштермен тікелій санауғу болады.
2. Санитарлы - көрсеткіш микроорганизмдер саны - СКМ - санитарлық микробиологияның өзіндік əдісі. Қоршаған ортаның əрбір объектісіне тəн санитарлы - көрсеткіш микроорганизмдер бар. Санитарлы - көрсеткіш микроорганизмдерге адам организмі мен жылы қанды жануарлардың асқазан ішек жолдары мен жоғары тыныс алу мүшелерінің облигатты микрофлорасының өкілдері жатады. .

.
СКМ - ге қойылатын талаптар:
• адам организмі мен жылы қанды жануарлардың бөлінділерінде əрдайым болу жəне қоршаған ортаға көп мөлшерде бөліну;
• адам организмі мен жылы қанды жануарлардан басқа табиғи резервуарлары болмауы қажет;
• қоршаған орта объектілерінде белсенді көбеюге қабілетсіз (тағамдық өнімдерден басқа) ;
• патогенді микроорганизмдерге қарағанда, қоршаған ортада ұзағырақ тіршілік ету;
• қоршаған ортада сыңарлары мен аналогтары жоқ;
• қоршаған ортада биологиялық қасиеттерін өзгертпейді немесе салыстырмалы аз өзгергіштік тəн;
• қоректік орталарда басқа микроорганизмдердің əсеріне тəуелсіз өсу қабілеті;
• қоршаған орта объектілерінде мүмкіндігінше біркелкі таралған;
• қазіргі кездегі қарапайы жəне жеңіл əдістер арқылы табылып, сандық көрсеткіші анықталып, идентификацияланатын болуы қажет;
• қоршаған орта мен ие организмде өзіне сəйкес патогенді микроорганизмдерге қарағанда, көп мөлшерде кездеседі

Санитарлы-микробиологиялық зерттеулердің принциптері.
Санитарлы- микробиологиялық зерттеулердің нəтижесіне əртүрлі факторлар əсер етуі мүмкін, сондықтан келесідей шарттарды орындау қажет: үлгілерді дұрыс алду; жүргізілетін анализдердің қайталану жиілігі; зерттеудің тек ғана станджартты жəне унифицирленген əдістерін қолдану; тестерді (тікелей жəне жанама) комплекті түрде қолдану; объектілерді бағалауды алынған нəтижелерді жинақтай отырып, жүргізу (органолептикалық, химиялық, физикалық жəне басқада əдістер арқылы алынған нəтижелерді ескеру) .

Санитарлы-микробиологиялық зерттеулердің принциптері.
БІРІНШІ ПРИНЦИП -азыктан дұрыс сынама алу. Санитарлык- микробиологиялык зерттеуде ен керектісі, ол катаң тексерумен, залалсыз- дандырумен сипатталады
ЕКІНШІ ПРИНПИП - қатарынан бірнеше анализ жүргізу, ол тексерілетін объектінің ерекшелігін тексереді, яғни су, ауа және әртүрлі микроорганизмдер болатын жерлер тексеріледі, олар әр жерде әртүрлі тараған, сонымен қатар микроорганизмдер бір бірімен биоценотикалық байланыста болады, бұл кейбіреулерінің өлуіне және басқаларының активті көбеюіне әкеп соғады.
ҮШІНШІ ПРИННИП - қайтадан сынама алу принципі, бұл сапалы, нақты қорытынды алу үшін керек. Бұл тексерілетін объектілердің барлық жағдайына (су, ауа) байланысты микрофлоралар уақытқа және кеңістікте өзгеріп отырады. Қоршаған ортаға зардапты микроорганизмдер аз мөлшерде түседі және онда бірдей тегіс таралмайды. Сондықтан сынамаларды екінші алу сыртқы орта обьектілерінің биологи- ялық контаминациясын анықтауға қажет.
ТӨРТІНШІ ПРИНПИП - стандартты және унифицирленген тексеру әдісі, бекітілген ГОСТ-лер мен инструкцияға сай лабораторияда салыстырмалы түрде алынады.

Санитарлы-микробиологиялық зерттеулердің принциптері.
БЕСІНШІ ПРИНПИП - комплекс тестілер арқылы зерттелетін обьектілерге әртүрлі санитарлық-микробиологиялық сипаттама беріп және оған баға беру үшін қолданылады. Зардапты микроорганизмдерді тексерудін тікелей және жанама әдістері бар, кейінгі әдіспен адам мен малдардын нәжісі арқылы сыртқы ортаның обьектілерінің ластануын анықтайды. Жанама тестілерге микробтардың жалпы санын, санитарлық көрсеткіш ретінде пайдаланатын микроорганизмдердің санын және олардың құрамын анықтау жатады.
АЛТЫНШЫ ПРИНЦИП - зерттелетін обьектілерге санитарлық- микробиологиялық тестілерді гигиеналық көрсеткіштермен бірге есептей отырып, алынған нөтижелерді жинақтап, баға беру ГОСТ-лар « мен нормативтерге (органолептикалық, химиялық, физикалық және тағы басқалар) сай келуі керек.
ЖЕТІНШІ ПРИНЦИП - санитарлық дәрігердің жауапкершілігі негізгі зерттелетін обьектілерге дұрыс қорытынды және тұжырымдау дәлдігі. Санитарлық- микробиологиялық зерттеудің арқасында тағамдық өнімдердің бұзылу дәрежесін, пайдалануға болама, пайдаланған жағдайда халықтың денсаулығына қауіпті емес екендігі анықталады. .

Сүт және оның ластану көздері.
- Іс жүргізу
- Автоматтандыру, Техника
- Алғашқы әскери дайындық
- Астрономия
- Ауыл шаруашылығы
- Банк ісі
- Бизнесті бағалау
- Биология
- Бухгалтерлік іс
- Валеология
- Ветеринария
- География
- Геология, Геофизика, Геодезия
- Дін
- Ет, сүт, шарап өнімдері
- Жалпы тарих
- Жер кадастрі, Жылжымайтын мүлік
- Журналистика
- Информатика
- Кеден ісі
- Маркетинг
- Математика, Геометрия
- Медицина
- Мемлекеттік басқару
- Менеджмент
- Мұнай, Газ
- Мұрағат ісі
- Мәдениеттану
- ОБЖ (Основы безопасности жизнедеятельности)
- Педагогика
- Полиграфия
- Психология
- Салық
- Саясаттану
- Сақтандыру
- Сертификаттау, стандарттау
- Социология, Демография
- Спорт
- Статистика
- Тілтану, Филология
- Тарихи тұлғалар
- Тау-кен ісі
- Транспорт
- Туризм
- Физика
- Философия
- Халықаралық қатынастар
- Химия
- Экология, Қоршаған ортаны қорғау
- Экономика
- Экономикалық география
- Электротехника
- Қазақстан тарихы
- Қаржы
- Құрылыс
- Құқық, Криминалистика
- Әдебиет
- Өнер, музыка
- Өнеркәсіп, Өндіріс
Қазақ тілінде жазылған рефераттар, курстық жұмыстар, дипломдық жұмыстар бойынша біздің қор #1 болып табылады.



Ақпарат
Қосымша
Email: info@stud.kz